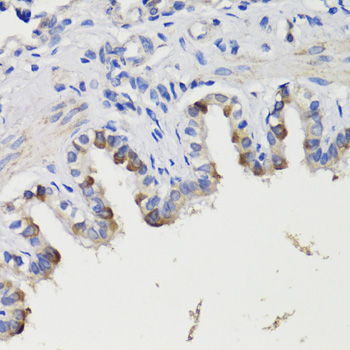

Primary
Product group Antibodies
ApplicationsWestern Blot, ELISA
ReactivityHuman
- SizePrice
Product group Antibodies
Anti-LHX5 AntibodyA92000
ApplicationsWestern Blot
ReactivityHuman, Mouse, Rat
- SizePrice
Product group Antibodies
Anti-Pea3 AntibodyA92006
ApplicationsWestern Blot
ReactivityHuman, Mouse, Rat
- SizePrice
Product group Antibodies
Anti-CGBP AntibodyA92007
ApplicationsImmunoPrecipitation, Western Blot
ReactivityHuman, Mouse
- SizePrice
Product group Antibodies
Anti-PFKFB3 AntibodyA92008
ApplicationsImmunoFluorescence, Western Blot, ImmunoCytoChemistry
ReactivityHuman, Mouse
- SizePrice
Product group Antibodies
Anti-PON2 AntibodyA92009
ApplicationsWestern Blot
ReactivityHuman, Rat
- SizePrice
Product group Antibodies
Anti-PRKAG3 AntibodyA92010
ApplicationsImmunoFluorescence, Western Blot, ImmunoCytoChemistry
ReactivityHuman, Mouse, Rat
- SizePrice
Product group Antibodies
Anti-Miz1 AntibodyA92013
ApplicationsWestern Blot, ImmunoHistoChemistry
ReactivityHuman, Mouse, Rat
- SizePrice
Product group Antibodies
ApplicationsImmunoFluorescence, Western Blot, ImmunoCytoChemistry, ImmunoHistoChemistry
ReactivityHuman, Mouse, Rat
- SizePrice
Product group Antibodies
Anti-Deptor AntibodyA92017
ApplicationsWestern Blot, ImmunoHistoChemistry
ReactivityHuman, Mouse, Rat
- SizePrice
Product group Antibodies
Anti-L2HGDH AntibodyA92018
ApplicationsImmunoFluorescence, Western Blot, ImmunoCytoChemistry
ReactivityHuman, Mouse
- SizePrice
Product group Antibodies
Anti-NeuN AntibodyA92020
ApplicationsWestern Blot, ImmunoHistoChemistry
ReactivityHuman, Mouse, Rat
- SizePrice
Didn't find what you were looking for?
Search through our product groups to find the right product
Back to overview
![Anti-FGF1 Antibody [KT115]](https://www.antibodies.com/image/catalog/0/A91_1.jpg)